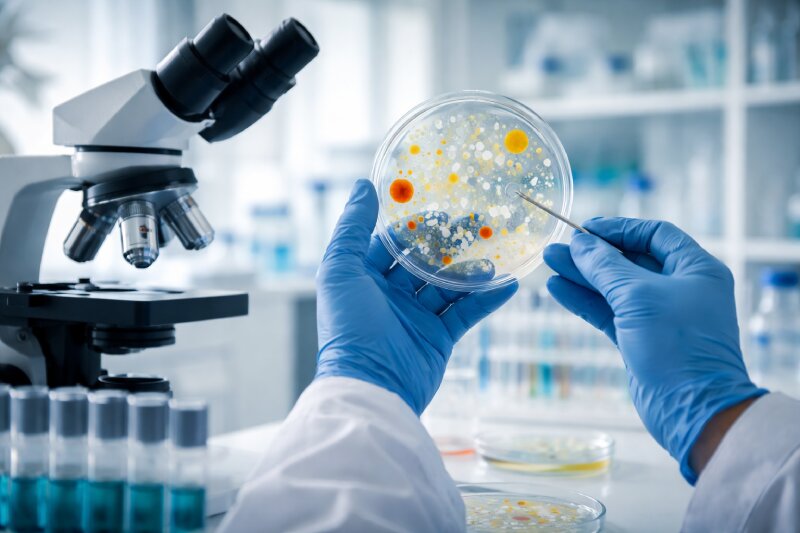

Welcome to M.S.LABORATORIES
Providing microbiological and chemical testing services since 1983

Who we are
M.S. LABORATORIES


Massa efficitur sed laoreet vivamus vel fames velit sem iaculis
Massa efficitur sed laoreet vivamus vel fames velit sem iaculis
Massa efficitur sed laoreet vivamus vel fames velit sem iaculis
Trusted by 25,000+ world-class brands and organizations of all sizes






Tempus lacinia adipiscing porta leo consectetuer ac tristique enim. Orci nullam tellus justo litora turpis diam.
Tempus lacinia adipiscing porta leo consectetuer ac tristique enim. Orci nullam tellus justo litora turpis diam.
Tempus lacinia adipiscing porta leo consectetuer ac tristique enim. Orci nullam tellus justo litora turpis diam.
Inspiring Discoveries from Our Global Research Team
97%
Consectetuer ac mus pulvinar mattis odio risus netus vestibulum parturient


Years of Experience
WHAT WE DO
We provide accurate, reliable testing solutions you can trust.

Why Choose Us
Reliable Testing You Can Trust
Project Done
Member Active
Client Reviews
Years of Experience

Our Service
Building A Sustainable Future Through Scientific Discovery
Ut vivamus duis habitasse phasellus dolor litora aptent montes nisl
Ut vivamus duis habitasse phasellus dolor litora aptent montes nisl
Ut vivamus duis habitasse phasellus dolor litora aptent montes nisl
Meet Our Team
Meet The Brilliant Minds Powering Syntalab Research Innovation

Research Director

Lead Biochemist

Chief Scientist

Lab Director
(888) 4000-2424
